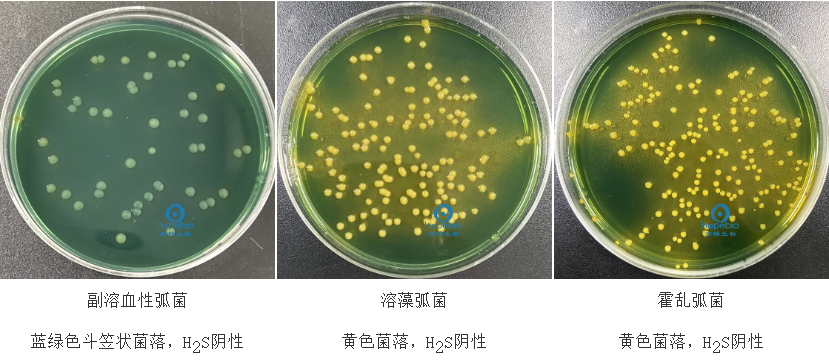

海博微信公众号
海博微信公众号
 海博天猫旗舰店
海博天猫旗舰店


 海博微信公众号
海博微信公众号
 海博天猫旗舰店
海博天猫旗舰店




溴麝香草酚蓝(Bromothymol Blue,简称BTB),又名溴百里香酚蓝,是一种酸碱指示剂、吸附指示剂,化学式为C27H28O5SBr2,易溶于乙醇、醚、甲醇及稀氢氧化碱溶液,稍溶于苯、甲苯及二甲苯,微溶于水,几乎不溶于石油醚。BTB是微生物学实验中常用的酸碱指示剂兼二氧化碳指示剂,其核心特性是对培养基pH变化和CO₂浓度高度敏感,且显色范围适配多数微生物的代谢环境,因此被广泛添加到各类培养基中,用于微生物的鉴别、筛选、代谢特性检测,是肠道菌、固氮菌、产酸菌等菌株鉴定的经典指示剂。
一、BTB的核心特性(培养基应用的基础)
BTB为浅玫瑰色结晶粉末,易溶于乙醇,微溶于水,其酸碱显色范围为pH 6.0~7.6,且能通过与CO₂结合生成碳酸间接降低培养基pH,实现显色变化,核心显色规律:
pH<6.0:黄色(强酸性,微生物大量产酸/产CO₂)
pH 6.0~7.6:绿色(中性/弱酸性,少量产酸/产CO₂)
pH>7.6:蓝色(弱碱性,微生物不产酸甚至产碱)
该显色变化可逆,且对微生物无毒性,不会影响菌株的正常生长。
二、主要应用场景
1. 鉴别细菌碳水化合物发酵能力
这是BTB最常见的用途,通过添加特定碳源(乳糖、蔗糖等),结合BTB颜色变化区分发酵型与非发酵型细菌。
(1)鼠李糖发酵鉴别
鼠李糖发酵管(用于单增李氏菌生化鉴定)中,BTB浓度通常为0.025 g/L。能发酵鼠李糖的细菌(如单增李斯特氏菌)产酸使培养基pH下降,BTB由绿色变为黄色;非发酵菌(如福氏志贺氏菌)不产酸,培养基呈蓝色或保持绿色。

图1 鼠李糖发酵管中细菌的生长特征
(2)蔗糖发酵鉴别
TCBS培养基(弧菌检测专用),含0.04 g/L的BTB及高浓度蔗糖。能发酵蔗糖的弧菌(如霍乱弧菌、溶藻弧菌)产酸,菌落及周围呈黄色;非发酵蔗糖弧菌(如副溶血弧菌)则保持培养基原有蓝绿色。
图2 不同细菌在TCBS琼脂上的生长特征
2. 碳源利用试验鉴别细菌
在枸橼酸盐培养基(如西蒙氏枸橼酸盐琼脂)中,BTB浓度为0.08 g/L,用于鉴定细菌是否能以枸橼酸盐为唯一碳源、铵盐为唯一氮源。能利用枸橼酸盐的细菌(如沙门氏菌属、克雷伯菌属)分解产物使培养基变碱,BTB由淡绿色变为深蓝色;不能利用的细菌(如埃希氏菌属、志贺菌属)则不改变培养基颜色。

图3 西蒙氏枸橼酸盐琼脂微生物质控结果
3. 监测细胞代谢活性(细胞培养场景)
在细胞培养基中,BTB可间接监测细胞呼吸产生的CO₂浓度。CO₂溶于培养基生成碳酸,导致pH下降,BTB随酸性增强从蓝色逐渐变为绿色、黄色,能直观反映细胞增殖速率和代谢状态,常用浓度为每10 mL培养基添加5滴0.1% BTB水溶液。
三、BTB在培养基中的配制与使用注意事项
BTB在培养基中为辅助试剂,需先配制母液,再按比例加入基础培养基,严格控制浓度和灭菌方式,避免显色失效。
1. 母液配制
取BTB 0.1 g,加0.05 mol/L氢氧化钠溶液3.2 mL使溶解,再加水稀释至200 mL。
2. 终浓度控制
加入基础培养基的终浓度为0.0004%~0.004%(常规为0.004%),浓度过高会抑制部分微生物生长,过低则显色不明显。
3. 灭菌与添加时机
BTB的耐热性较差,121℃高压蒸汽灭菌会分解失效,因此需将基础培养基高压灭菌后,冷却至50℃~60℃(琼脂未凝固),再无菌操作加入过滤除菌的BTB母液,摇匀后倒平板/装管。
4. 培养基初始pH
基础培养基需调节至pH 7.0~7.2(弱碱性),使BTB初始显色为蓝色,保证微生物代谢的pH变化能被准确反映。
5. 避光培养与保存
BTB对紫外线和可见光敏感,长期光照会分解褪色,因此配制好的BTB培养基需避光保存,培养过程中置于避光培养箱,避免环境光干扰显色。
6. 排除环境CO₂的干扰
培养基中的BTB会与空气中的CO₂结合产酸,导致空白培养基变绿,因此液体培养基需密封培养(如杜氏小管发酵管加塞),固体培养基倒平板后尽快使用,避免长时间暴露在空气中。
7. 适配基础培养基的营养体系
BTB仅反映pH的变化,需保证基础培养基的营养成分(碳源、氮源)适配目标菌株,如固氮菌筛选需用无氮培养基,糖发酵试验需用单糖培养基,避免营养杂糅导致pH变化误判。
8. 显色结果的时效性
多数微生物的产酸/产碱代谢在培养24 h~48 h达到峰值,此时显色结果最准确;培养时间过长(>72 h),培养基水分蒸发或菌株自溶会导致pH异常,需及时观察结果。
四、小结
BTB是微生物培养基中通用性最强的酸碱/CO₂指示剂,其核心价值在于将微生物的代谢特性转化为直观的显色变化,实现快速鉴别与筛选,是微生物学基础实验、工业菌株选育、环境微生物检测中的经典试剂。
五、产品展示
我公司有各种含溴麝香草酚蓝的培养基,客户可根据实际情况和用途进行选用。
表1 产品信息
|
产品货号 |
产品名称 |
规格 |
用途 |
|
HB4130 |
250g/瓶 |
用于致病性弧菌的选择性分离 |
|
|
HB0115-1 |
250g/瓶 |
用于蜡样芽孢杆菌利用柠檬酸盐试验 |
|
|
HB0115 |
250g/瓶 |
用于肠道菌的柠檬酸盐利用试验(GB标准) |
|
|
HB7031 |
250g/瓶 |
用于尿液中细菌的分离培养和计数 |
|
|
GS011 |
20支 |
用于O157、沙门氏菌、志贺氏菌、阪崎杆菌、蜡样芽胞杆菌、变形肠杆菌的生化鉴定 |
|
|
HB8468 |
250g/瓶 |
用于细菌甘露醇发酵试验(GB标准) |
|
|
GB032 |
20支 |
用于单增李氏菌生化鉴定 |
|
|
GB007 |
20支 |
用于蜡样、沙门、志贺氏菌的生化鉴定 |
|
|
GB029 |
20支 |
用于单增李氏菌生化鉴定 |
|
|
GB021 |
20支 |
用于志贺氏菌生化鉴定 |
|
|
GB012 |
20支 |
用于沙门氏菌和志贺氏菌生化鉴定 |
|
|
GB014 |
20支 |
用于沙门氏菌和志贺氏菌生化鉴定 |
|
|
GB018 |
20支 |
用于沙门氏菌和志贺氏菌生化鉴定 |
注:本文属海博生物原创,未经允许不得转载。
下一篇:培养基中常用的胨类及其作用
| 相关文章: |



